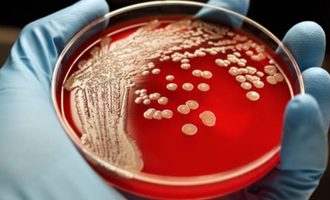

Οι παγετώνες που λιώνουν απελευθερώνουν πανάρχαια άγνωστα μικρόβια
Υπάρχει ένας ακόμη λόγος που η κλιματική αλλαγή ενέχει κινδύνους. Μπορεί να οδηγήσει σε τήξη πανάρχαιων πάγων μέσα στους οποίους…
Περισσότερα »
Μικρόβια επιβίωσαν εκτεθειμένα στο διάστημα στο εξωτερικό του ISS
Η ανακάλυψη ότι συγκεκριμένα μικρόβια μπορούν να επιβιώσουν στο εξωτερικό του ISS δίνει νέες οπτικές στην αναζήτηση εξωγήινης ζωής από…
Περισσότερα »
Απίστευτο: Ο Κιμ Γιονγκ Ουν χτίζει εργοστάσια μικροβίων, για να αποκτήσει βιολογικά όπλα
Οπλοστάσιο βιολογικών όπλων, ικανών να προκαλέσουν το θάνατο δεκάδων χιλιάδων ανθρώπων προσπαθεί πιθανότατα να αποκτήσει ο Κιμ Γιονγκ Ουν, εκτιμούν…
Περισσότερα »
Γιατί δεν κάνει να πίνουμε νερό από το ποτήρι που έχουμε δίπλα μας το βράδυ (βίντεο)
Πολλοί άνθρωποι έχουν τη συνήθεια να αφήνουν ένα ποτήρι με νερό στο κομοδίνο δίπλα από το κρεβάτι τους, όταν πέφτουν…
Περισσότερα »
Εφιάλτης: Το πρώτο κρούσμα ασθενή που δεν τον “πιάνει” κανένα αντιβιοτικό
Τους χειρότερους εφιάλτες για την επιβίωση της ανθρωπότητας έρχεται να επιβεβαιώσει το περιστατικό του πρώτου ασθενή στον οποίο δεν «πιάνει»…
Περισσότερα »
Σοκ: Ένας θάνατος ανά τρία δευτερόλεπτα από μικρόβια προβλέπει έρευνα
Εάν δεν αλλάξει κάτι μέχρι το 2050, ένας άνθρωπος θα πεθαίνει από τα μικρόβια κάθε τρία δευτερόλεπτα, σύμφωνα με επίσημη…
Περισσότερα »
Δεν θα το πιστέψεις πόσα μικρόβια μεταδίδονται με ένα παθιασμένο φιλί
Ένα παθιασμένο φιλί, το οποίο διαρκεί αρκετά δευτερόλεπτα είναι σίγουρα ένας από τους καλύτερους τρόπους για να ανέβει η λίμπιντο…
Περισσότερα »